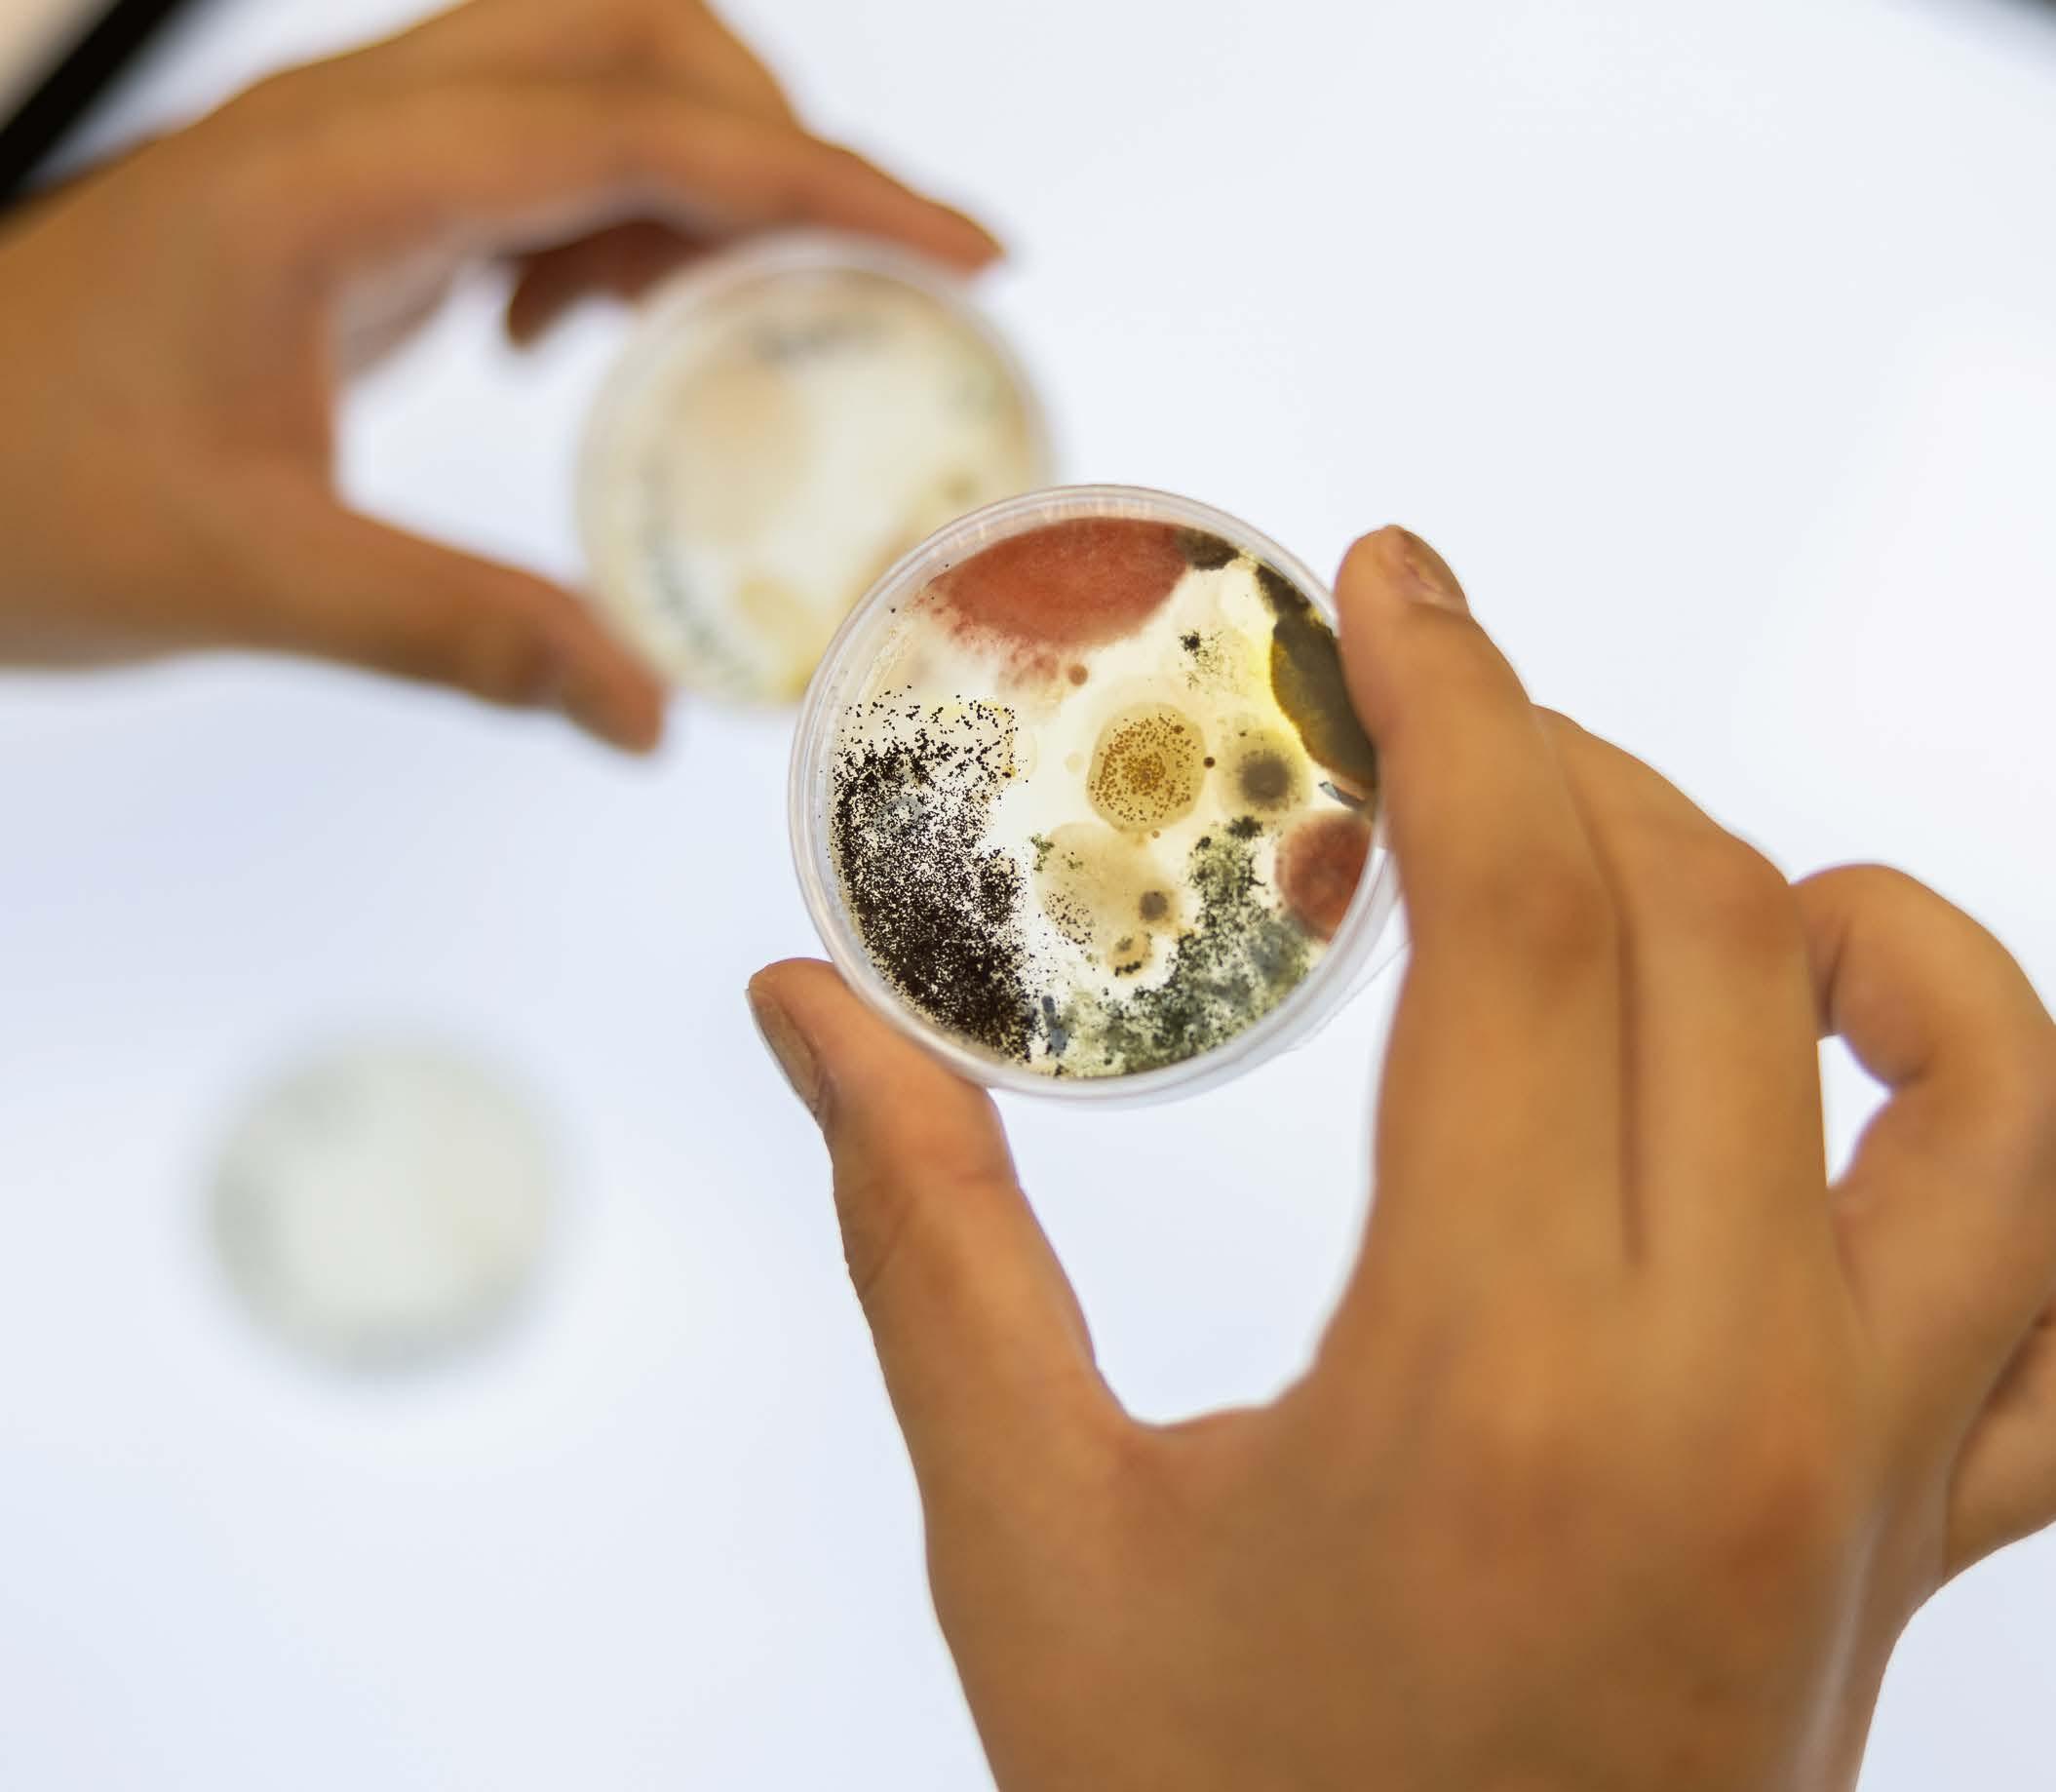

Minor magazine 2025-2026



Avans Creative Innovation offers a wide and innovative range of minors. All programs are worth 30 ECTS credits and take place during the fall semester. Only Studio You is offered in both semesters.
The minor courses are taught by knowledgeable and dedicated lecturers from the following programs:
• Business Innovation
• Communication & Multimedia Design Breda
• Koningstheateracademie
- Performance in Art
• St. Joost School of Art & Design
- Art & Research
- New Design & Attitudes
- Illustrated & Animated Storytelling
- Photography, Film & the Digital
We hope to see you next academic year in one of the minors at Avans Creative Innovation!
You can register for a minor at Avans Creative Innovation starting from early February 2025. It is advisable to arrange your registration as soon as possible.
As an exchange student, you will continue to pay tuition fees to your home institution. This means you do not have to pay tuition fees to Avans.
If your university is not a partner of Avans University of Applied Sciences, you can join us as a full-fee paying student. For more details, please contact the Avans International Office on +31 88 - 525 80 01 or at internationaloffice@avans.nl .
Some minors have an admission procedure. After registering, you will receive information on how the admission process works.
A selection of minors is also open to international students. In such cases, the language of instruction will be indicated as English.
If you have any questions about registration, please email minoren.aci@avans.nl.

Write Loud!
Material Ecologies
Development for Visual Storytelling
Joost I Photography and the Digital Breda 20 weeks, 30 ECTS Dutch|English Sept Yes
Joost I New Design & Attitudes Breda 20 weeks, 30 ECTS Dutch|English Sept Yes
Joost I Illustrated & Animated storytelling
Joost I Illustrated & Animated storytelling ’s-Hertogenbosch
Moggré Innovation Managament & Creative Leadership Business Innovation ’s-Hertogenbosch 20 weeks, 30 ECTS English Sept Yes
van den Dool

Form: Full time
ECTS: 30
Location: Breda
Period: September - January
Introduction
Write LOUD is where your guts use their voice and your ideas grow legs—because the stories inside you didn’t come here to stay quiet. This isn’t just a minor; it’s a permission slip to create, fail, run, fall, jump and learn to trust your voice enough to use it.
By choosing Write LOUD you want to stretch yourself and make work that resonates and kicks. This is a minor for building tools, to experiment and grow with writing, and push your ideas further. It’s where you’ll find your voice in/on and around words, using creative writing tools to challenge yourself and your visual practice. Expect to build your craft through trial, feedback, and reflection, and putting yourself out there, all with the result of having written work with a beating heart.
In Write LOUD we focus on building your toolkit. Skills such as editing, maintaining flow, feedback loops, role of research, idea shaping and the very act of showing up and writing consistently. In this course you will discover how to create a practice of writing that meets your needs as an artist, designer, maker in whatever form you chose. We encourage students to find their form across genres and mediums. We share the many ways of how story building can work and offer you the tools to create your own approach. We solidly believe that by creating work (making meters) you can help strengthen your capacity to elicit nuance, to develop suspense, to reach audiences, and to make work of meaning. For you, for your audience.
Who joins this minor?
You are hungry for a good story and want to be the person who tells it. You are ready to spend six months working on something YOU love, and gets you excited about getting up in the morning. You are looking for a way to explore how writing can further your visual
Language: Dutch|English
Admission: Yes
Coordinator: Juliet Gagnon
Level: Bachelor
practice or simply want the time to be able to expand your writing and telling skills. This is a minor for folks with a passion for what they do. Or folks who want that passion back.
What you will do during this course
You will write. You will read. You will listen. You will engage.
You will not be perfect. You will not get everything right, but you will show up and dig in.
During the course of 20 weeks students will develop a media (mixed or hybrid) project with writing as the foundation. The forms are open and you will learn which form best supports your story (think of podcasts, chapbooks, graphic novels, the potential is endless). We work with guest lectors from the US, UK and Netherlands in and out of the classroom. We work in feedback sessions with the group and with the core faculty. There is a solid focus on what the GROUP dynamic can bring to your individual work so be prepared to get close. This is not an isolated experience. You will not be alone in your attic writing but you will learn how to define your work as an individual. This is a practice that builds on the understanding that making art is a collective experience.
You will work on a project for the duration of the minor. Think of projects such as a podcast, chapbook, graphic novel, short stories in video and more. Under guidance you will select the form that works best for your theme, material, goals. You will have small short assignments and will work intensively with a number of faculty. Throughout the course, you will meet twice a week for engaging sessions featuring guest speakers, workshops, and inspiration days developed

in collaboration with Watershed and the Lazy Listeners Festival. These sessions, designed to spark creativity and expand your knowledge, will take place onsite, online, or off-site as indicated in the course overview, which provides clear details about when, what, and where.
Over the years, we’ve been privileged to host an impressive lineup of speakers who are flourishing in their field. Past contributors include Leonieke Baerwaldt, Corinne Heyrman, Dwight Fagbamila, Erik Jan Harmens, Mirjam van Dijk, Stan van Herpen, Buddy Wakefield, Michelle Samba, Jerron Herman, and Kevin Toma. These heavy hitters bring unparalleled expertise and insights, making this course a unique opportunity to learn from folks with fire.
Good to NOTE: There will be some classes in the evening and online in connection with guest lectures from the US, Canada and elsewhere- it is required to attend. There are also classes in connection with the Lazy Listeners Festival December 5th and 6th Area 51 Eindhoven. This festival is required to attend.
What do you need to apply?
• You need to love writing, you do NOT have to already be great at it but there needs to be a willingness to learn, to be open to coaching and editorial feedback.
• You need to have an idea of something you want to work on
• Entry to this course requires a starting point. What is the story you come here to tell. It can start with something as simple as a theme, or an event, or something that you already have had laying in your desk drawer for years- but we start with a seed. In the admission application we want to see a short description of your focus (200-500) and why this interests you.
• English reading/speaking is required for the course to a level of B2/C1
• You are not required to produce work in English

Form: Full time
ECTS: 30
Location: Breda
Period: September - January
Introduction
Are you concerned about the ecological crisis and want to play an active role? In Material Ecologies, you’ll learn to understand, imagine, and address the ecological crisis through a combination of creativity, research, and practice, with materials as the central focus.
You will explore the material stories behind objects and artworks. Consider a wooden table: where does the wood come from? From the store to the sawmill, to the forest. Who cut down the tree, and who processed the wood? What were the ecological relationships surrounding that tree? How old was it, and what was the world like when it started growing? And: what happens to the table when it breaks—end of the story, or a new beginning?
In addition, you’ll examine broader ecological systems. How does your work impact human and non-human life? What new connections can you create between materials, technologies, and natural processes?
At Material Ecologies, you’ll work hands-on in workshops with materials like wood, clay, or textiles. In the biolab—Material Incubator, you’ll experiment with microorganisms. At the same time, we’ll ask critical questions: What do we consider to be a material? Are organisms like seaweed a material? Can digital data— the bits and bytes—also convey a material narrative? By observing, researching, and working with your hands, you’ll develop practical skills and translate your insights into compelling visual stories. The program emphasizes collaboration with the field, as we believe shared knowledge and partnerships are key.
Language: Dutch|English
Admission: Yes
Coordinator: Annemarie Piscaer
Level: Bachelor
Within the minor, we collaborate intensively with professionals in the field, as we believe shared knowledge and partnerships contribute significantly. Over the past year, we have worked with researchers from Caradt, attended symposia at institutions such as Radius, the center for ecology and art in Delft, and visited the Textile Museum, the European Ceramic Work Centre (EKWC), and Het Nieuwe Instituut in Rotterdam.
Additionally, we participated in workshops led by experts. In Breda’s academy garden, we created masks from found materials under the guidance of minor tutor Annemarie Piscaer. Designer Simon Dogger, who uses his auditory and sensory perception as a blind creator, taught us to experience our material environments differently. Bio-artist Michaela Davidová introduced us to working in the Material Incubator lab with microorganisms.
In the lab, we studied our soil by developing Anthotype with Steffie de Gaetano and explored making photographic prints with alternative natural materials with Risk Hazekamp. At the Avans lab in Breda, Robert Knight conducted a workshop on combining PLA with textiles.
Finally, the students themselves contributed their expertise by teaching one another about moss and mycelium through field trips in the forest, working with seaweed, and making kombucha in the lab. They also taught each other skills such as weaving, knitting, and throwing clay on the wheel.
Research: Explore Material Ecologies through a curriculum that combines theoretical and philosophical insights with artistic research.
Experiment and Create: Experiment with various materials and techniques in workshops and the biolab.
Inspire and Communicate: Present your research through image and visuals, process, and final work through a shared website, showcasing your creations in a broader context and connecting with the professional field.
Admission requirements
To join this programme,you do not need to take any admissions test.You are expected to bring a curious attitude.
Get inspired
Follow this link and explore the projects of students who have taken the minor this year.

Form: Full time
ECTS: 30
Location: Breda
Period: September - January
What wil you learn
This minor at St. Joost focuses on the development of animated TV shows, animated films, animated narrative games, or concepts that work across all these platforms.
You will learn to effectively tell the core of a story, create art to visualize it, and transform the idea into a professionally crafted pitch package, including an animated teaser. How do you create such a proposal that could convince producers, funders, broadcasters this idea is worth making?
To participate in this minor you have to take an admission test.
Learning goals
• Develop ideas into a compelling narrative.
• Enhance your (technical and other) skills relevant to your chosen role.
• Create a comprehensive pitch package that integrates story, artwork and teaser, and present it in a professional manner.
• Undertake visual and theoretical research.
• Make well-founded decisions regarding target audience.
• Reflect on your artistic and professional position.
• Collaborate within a team in a studio setting.
• Constructively handle feedback from professionals.
• Demonstrate a high level of independence in your work.
Language: Dutch|English
Admission: Yes
Coordinator: Frank Verheggen
Level: Bachelor
The assessment is integral. At the end of the minor you will be assessed on:
• Visual storytelling (10 EC)
• Research & development (10 EC)
• Positioning (10 EC)
The final assessment looks at the level of your work, your research and your contribution during the lessons.Halfway through the program you have a progress review. You will receive feedback from your teachers. You will learn whether you are on track and what you still need to do to reach the final level.
You work in a studio setting, forming teams, making partnerships. In student teams, you do research and create work. As a team, you work with a high degree of independence. You learn to make effective use of each other’s qualities.
During the minor, you go through two short cycles where, these small teams develop an idea into a pitch. A series of masterclasses directly align with the steps taken in these cycles. Over the past three years, students have had the opportunity to engage with professionals such as Mark Hoffmeier (USA, Spider-Man, Power Rangers, LEGO Marvel Super Heroes), Patrick O’Keefe (Into the Spiderverse), Edwin Rhemrev (NL, Despicable Me 3, Minions - Rise of Gru, Over the Moon, The Grinch), Kenneth Anderson (UK,

Dreamworks TV, BBC CeeBeeBies, Imagine FX), Esther Morales (ESP, Cartoon Network, Netflix, Cartoon Saloon), Ethan Becker (USA, Netflix, Dreamworks, Warner Bros), and many others. During these classes, students receive comprehensive feedback on their work and ideas.
At the end of the first two cycles, a panel from the industry selects the five best ideas, and for these chosen projects, students create an animated trailer in the final cycle.At the end of the minor, students present all final projects to an international jury for the Keep An Eye Development for Visual Storytelling Award.
This minor offers you the opportunity to take the first steps towards specializing in a field of development and pre-production in animation. Perhaps your talent lies in scenario writing or story-boarding? Or are you a character designer or world-builder? Are you interested in concept art, title design, paneling, animation? Or are you more into audio, coloring, graphic design, art direction, making 3D models? Maybe you are a creative
producer.You will have the opportunity to explore this in depth a number of times and you will sometimes take on multiple roles within a production.
You will investigate your chosen role,the theme of the story,visual approach,technical realization, and target audiences, stages, and platforms. Reflection on the production will also be done collectively.
Follow this link and watch a video about this minor, where several students talk about their projects.
Form: Full time
ECTS: 30
Location: ’s-Hertogenbosch
Period: September - January
Introduction
In this minor, you will collaboratively create a stopmotion animated film as a team. You will explore your role in the stop-motion production team and collectively shape a story featuring multiple characters. You will create puppets and scale models for the set, utilizing the workshops available at the academy (e.g., woodworking, 3D print shop). You will attend animation classes, understand essential elements for a stop-motion story, and experiment with suitable design and material usage. Together, you will go through the entire process from storyboarding to shooting to the premiere.
This programme is designed for students who enjoy storytelling, analogue work, and anyone interested in experiencing the production process of a stop-motion film. Enjoy the possibility to work on an animation for a semester!
Program structure
Learning Objectives
• Designing a story for a stop-motion film with multiple characters
• Using storyboarding, framing, and camera perspectives
• Creating blueprints for characters and sets
• Building animatable puppets
• Designing and constructing a scale model set
• Experimenting with basic animation skills for stopmotion
• Lighting your set (tabletop photography)
• Working with an animation camera and the Dragon Frame program
• Collaborating in a team
• Exploring your role in a team
• Basic editing, post-production, and sound editing
Language: Dutch|English
Admission: Yes
Coordinator: Paul Moggré
Level: Bachelor
Assessment
At the end of the semester, you will be assessed on your story, designs, work process, and final results, considering communication and visual design as well as the responsibility you take within the team. Both formative and summative assessments will be conducted.
• Admission requirements
• Studying at an art academy or a related program
• Completed your propaedeutic year
• Willingness to collaborate in a team
• Awareness that animation takes time and requires patience
• Sufficient creativity and visual imagination
Admission procedure
The selection is based on a portfolio and a motivation letter. Once you apply, you will receive more information about the requirements.

Form: Full time
ECTS: 30
Location: ’s-Hertogenbosch
Period: September - January
Introduction
Step into the future with Innovation Management & Creative Leadership. This minor is...
• A hands-on programme.
• Mastering the art of innovation.
• Learning how to lead the process of developing creative solutions.
• Working from the get-go on real-world projects for leading international companies.
• Being a part of shaping a sustainable future.
The world is evolving at lightning speed. Competition is fierce, and product life cycles grow shorter by the day. To stay ahead, organisations are seeking tomorrow’s trailblazers—visionary professionals who combine creativity and innovation with the courage to forge new paths.
This is your chance to make a difference. Join the Innovation Management & Creative Leadership programme, a forward-thinking minor focused on learning-by-doing. Work together in dynamic project teams to solve real-world challenges presented by leading companies. Through this practical approach, you’ll broaden your expertise and gain valuable knowledge and experience that will benefit you throughout your entire professional career. Whether you aim to drive change and improvement through creativity, strategy, or technology. Think boldly, act with determination, and design solutions that shape the future.
Language: English
Admission: Yes
Coordinator: Karin van den Dool
Level: Bachelor
• Master the art of innovation
• Take charge of the creative journey to develop groundbreaking products, services, or concepts.
• Transform ideas into action: prototype, test, refine, and build for real-world impact.
• Drive entrepreneurial success while contributing to a more sustainable world.
• Discover the leader within you and start building a future that matters.
Program structure
- This minor is led by industry experts with years of experience in the business world. They have designed the programme to ensure you can apply all the knowledge, tools, and methods directly in practice. Throughout the minor, you will engage in both individual and group assignments, navigating all stages of the innovation process—problem finding, ideation, concepting, and implementation.
- The minor is structured around 2 key areas: innovation management and creative leadership. These are closely intertwined to master the innovation process. Within these 2 areas, you will participate in a variety of courses:
Innovation management
Trendwatching
Innovation research
Innovation theories
Business models
Change management
Project management
Creative leadership
Creative thinking
Brainstorming
Concept testing
Prototyping
Facilitation
Leadership
Throughout the minor, you will work on 2 projects focused on real innovation challenges for actual clients. Last year those clients were for example SAP and Nestlé. In teams of 4-6 international students, you will collaborate closely with both the client and lecturers to develop practical, impactful solutions. You’ll experience firsthand how to transform an idea into a fully developed concept and successfully launch it. This immersive and practical approach equips you with the skills to thrive in real-world innovation challenges.
By completing this minor, you will emerge as a knowledgeable, creative, and innovative leader capable of developing groundbreaking businesses. You will learn to identify real innovation challenges, generate new ideas, and develop and test concepts using the innovation cycle, research methodologies, creative techniques, and innovative tools. You will gain the skills and knowledge to work effectively in a multidisciplinary, international, and culturally diverse context. All while adopting an open mind, and an entrepreneurial, responsible, and creative mindset.
In addition to actively participating in workshops, students are required to complete various projects, both individually and in groups. The learning outcomes will be assessed through an individual presentation and a portfolio. Midway through the minor, you will undergo an assessment by a panel of 2 teachers. At the end of the minor, during the final high-stakes assessment, you will present and discuss your growth and development as a business innovator. Based on your activities throughout the course, the teaching staff will make a well-informed decision. If you demonstrate that you have met the learning outcomes, you will be awarded 30 ECTS.
Is Innovation Management & Creative Leadership the right fit for you?
• Are you curious and open to new ideas, people, technology and cultures?
• Do you want to master the process of developing and implementing
• new products, services, ideas or systems?
• Are you eager to work on real-life challenges for actual clients in an interactive, creative, and hands-on environment?
• Do you wish to explore and enhance your creative leadership skills to discover the ideal balance between creativity, practicality, and business value—what we call the ‘Innovation Sweet Spot’?
• You can participate in an exchange programme at Avans University of Applied Sciences if your home institution has concluded an agreement with Avans. Under this agreement you can be nominated to study with us.
• Please read the details on the Applying as an exchange student page or contact your home institution’s exchange coordinator for details. Alternatively, you can join us as a freemover.
• Important: The Avans education linked to this exchange module is: Business Innovation Den Bosch (BINNO-H)
• This information you will need for the enrolment on Studielink.

You can participate in an exchange programme at Avans University of Applied Sciences if your home institution has concluded an agreement with us.
Please contact your home institution’s exchange coordinator to find out if this is the case.
As an exchange student, you will continue to pay tuition fees to your home institution. This means you do not have to pay tuition fees to Avans.
If your university is not a partner of Avans University of Applied Sciences, you can join us as a full-fee paying student. For more details, please contact the Avans International Office on +31 88 - 525 80 01 or at internationaloffice@avans.nl .
If you would like more information about studying at Avans, please contact our International Office: internationaloffice@avans.nl +31(0)88 - 525 80 01
Questions about the program? Ask them through: minoren.aci@avans.nl